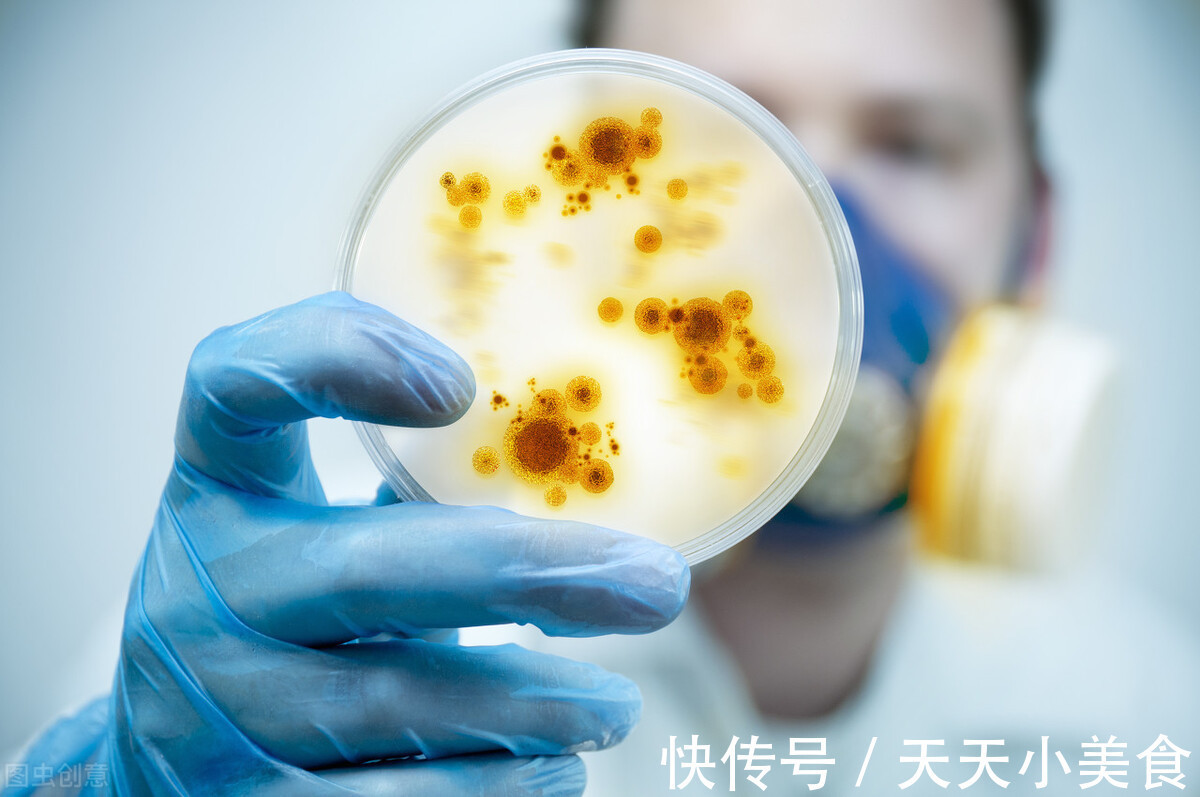
长期久坐|应注意这三个主要因素或导致妇科疾病复发的主要原因

女性最重要的两个部位是生殖系统和乳房,女性应该特别小心。因为这两个部位非常脆弱,如果不小心很容易受到病毒的攻击,导致女性患有各种疾病,会影响健康,从而严重影响正常生活。

文章插图
应注意这三个主要因素或导致女性妇科疾病总是反反复复的重要因素,要时刻保持警惕
1.长期久坐不运动
俗话说,生命在于运动。长期久坐而缺乏足够的运动,这是妇科疾病反反复复的重要原因之一。长期久坐,身体的血液循环不畅,不仅不能给女人的秘密区提供足够的血氧,而且久坐,女人的秘密区也被封闭了.在闷热的环境中,私处很容易接触到病菌,从而导致一系列妇科疾病或妇科炎症。要在日常的工作和生活中避免长期久坐,隔一段时间起身走一走,要运动起来以改善体内血液循环,保护女性的健康。

文章插图
2.长期不健康的生活方式
对于女性朋友来说,如果您患有妇科疾病并且经常复发,这可能是由于您多年来养成的不良习惯或不健康的生活方式。由于社会的不断发展,女性的角色也在不断变化,社会对女性的要求越来越高,往往使她们承受着巨大的生活和工作压力。

文章插图
为了缓解这种压力,很多女性往往养成熬夜、长期吸烟、饮酒等不良生活习惯,长此以往不仅会降低,还会损害女性的抵抗力。各种细菌入侵人体免疫系统。
而如果女性平日不注意个人卫生,妇科疾病复发的可能性就会增加。因此,长期不健康的生活方式是女性妇科疾病复发的主要原因之一。

文章插图
3、清洁方法不正确
许多女性认为,用各种隐私清洁液或一些草药清洗隐私区域,以防止妇科疾病的发生,可以保护女性隐私区域的健康。其实这个方法是错误的,如果长期用所谓的清洁液或草药清洁女人的秘密区域,不仅容易破坏女人秘密区域的有益菌,导致菌群失调,还会损害免疫系统。私人空间容易受到各种病菌的侵害,反复发作一系列妇科疾病。
文章插图
一些炎症反反复复的主要原因就是微生态菌群失衡,需要通过补充益生菌,增加有益菌数量,抑制害菌的繁殖,调节微生态,促进菌群平衡,从而缓解炎症,防止复发。

文章插图
【 长期久坐|应注意这三个主要因素或导致妇科疾病复发的主要原因】因此,为了避免妇科疾病的复发,女性应提高警惕,避免这三个引起妇科疾病的因素。
- 长期在睡前玩手机的人,身体若出现4个迹象,或是肝在“求救”
- 健康|请查收|有助于长期保持健康的6个小方法
- 便秘|长期便秘怎么办?
- 李明蔚|抗癌歌手李明蔚病情恶化,长期卧床行动不便,已无药可治听天由命
- 熬夜|长期熬夜者DNA损伤多,癌症风险大!这3种熬夜方式最伤身体 .
- 甲状腺癌|得了癌症就代表只能等死?辟谣:这3类人可以长期生存,甚至长寿
- 关键|不让尿毒症上门来,关键是做好这4件事,要长期坚持
- 长期缺少“爱情滋润”的女人,有四个特点可能很明显,藏也藏不住
- 安全套安全吗?女性长期用安全套,有些麻烦或会找上你,别轻视
- 长期吃“挂面”会引起甲减?医生提醒:患甲减,多吃3物或有帮助
